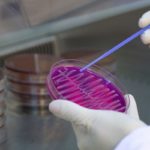

FABRÍCIO SILVEIRA
Jornalista e professor universitário
O nome do semioticista italiano Umberto Eco (1932-2016) voltou recentemente à tona com a reedição de um texto escrito em 1995, por ocasião de uma conferência proferida na Universidade de Columbia (EUA).
“O fascismo eterno” – esse é o título daquela comunicação – foi traduzido para diversos idiomas e acabou incluído no livro Cinco Escritos Morais, lançado no Brasil em 1998, pela editora Record.
Além de celebrar o legado de um dos mais destacados intelectuais dos últimos 50 anos, a nova edição de O Fascismo Eterno (Record, 2018) – uma bonita edição de bolso – é também sintomática de um conjunto de preocupações sócio-políticas então emergentes em nosso atual debate público.
FABRÍCIO SILVEIRA – Opinião: O avesso do bom senso
E o que nos diz Umberto Eco? Num primeiro momento, expõe suas lembranças pessoais como jovem fascista italiano, com cerca de 11 anos de idade, cooptado pela retórica inflamada – o “virtuosismo retórico” – de Mussolini, no interior da Itália, na primeira metade da década de 1940.
A partir daí, o que se segue são relatos breves sobre o fim da Segunda Guerra, sobre a vitória da Resistência e sobre os sentidos da palavra “libertação”.
O autor descreve o contato que teve com os primeiros soldados norte-americanos.
“O primeiro ianque que encontrei era um negro, Joseph, que me apresentou às delícias de Dick Tracy e Ferdinando Buscapé” (p. 11).
FABRÍCIO SILVEIRA – OPINIÃO: O eterno retorno do fascismo (III)
Aos poucos, o que era uma digressão pessoal, feita ao sabor da memória, se converte numa das mais lúcidas e fluentes reflexões de que hoje dispomos sobre a natureza do fascismo.
Eco emprega a expressão “UrFascismo” para se referir a um fenômeno político e ideológico tão persistente quanto difícil de definir em termos brutos, com invariável objetividade.
O fascismo é sempre um fascismo fuzzy, ele diz.
FABRICIO SILVEIRA – Opinião: O eterno retorno do fascismo (II)
Ou seja: não é “uma ideologia monolítica, mas antes uma colagem de diversas ideias políticas e filosóficas, um alveário de contradições” (p. 32).
Uma “nebulosa de instintos obscuros e pulsões insondáveis” (p. 23), Eco reconhece.
Alguma coisa, no entanto, se pode depreender como parte dessa colcha de retalhos. Os fragmentos desse mosaico – essa mistura de afetos, disposições psíquicas e ideais políticos –, segundo o autor italiano, seriam:
FABRÍCIO SILVEIRA – Opinião: O eterno retorno do fascismo (I)
1. O culto da tradição
2. A recusa da modernidade
3. A ação pela ação – a suposição de que um homem de ação é mais valoroso, por princípio, do que um sujeito culto e intelectualizado
4. O desacordo como traição
5. O medo da diferença (o racismo implícito e/ou explícito)
6. O apelo às classes médias frustradas
7. A obsessão com toda forma de conspirações
8. A ideia do adversário, ao mesmo tempo, como forte demais e fraco demais
9. A ideia de que o pacifismo é um conluio com o inimigo
10. O desprezo pelos fracos (o repúdio às minorias)
11. A educação para o heroísmo
FABRICIO SILVEIRA – Opinião: Tolos, fraudes e militantes
12. O machismo
13. O populismo qualitativo
14. A “novilíngua” (o emprego de uma linguagem própria, cifrada, com inversões estratégicas de sentido).
O fascismo eterno, portanto, seria capaz de recombinar e recolocar permanentemente esses ingredientes.
Jornalista, roqueiro e escritor de Santa Maria estreia no Paralelo
Seria capaz de alterar-lhes a ênfase, encobri-los e repotencializá-los, conforme as necessidades de sobrevivência e enfrentamento do jogo político, de acordo com a distração dos adversários, o senso e o clamor das oportunidades.
Para Umberto Eco, é assim que o fascismo se enraíza entre nós, mesmo em trajes civis. Uma democracia plena e pulsante é aquela que melhor aprende a se manter em vigília.

No Comment! Be the first one.